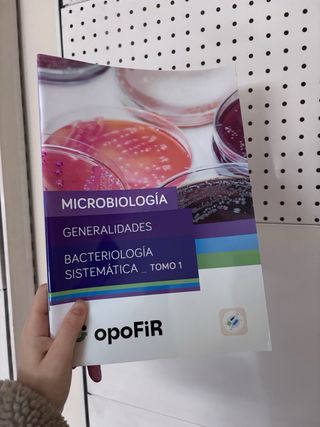

Libros, música y películas de segunda mano Benalup-Casas Viejas
Novedades
MANUALES FIR 2024/2025
Se vende todo el material de la academia OPOFIR correspondiente al curso 2024/2025. Incluye: -Manuales de todas las asignaturas: Fisiopatología, Farmacología, Químicas, Microbiología y Parasitología, Biología Molecular, Bioquímica, Análisis Clínicos, Inmunología, Biofarmacia y Farmacocinética, Técnicas Instrumentales, Misceláneas y Galénica -Simulacros en papel -Desgloses en papel NOTA 1: están TODOS sin subrayar, solo a excepción de 3 páginas del primer manual de fisiopatología (ver en foto número 10) NOTA 2: en las fotos no aparecen todas las asignaturas porque no deja subir más
Un corazón para dos de Jessi Kirby
Novela romántica y juvenil
Wild Love de Elsie Silver
Novela juvenil en inglés
Un cuento perfecto de Elísabet Benavent
Novela romántica
Baquetas PROMARK MJZ 7 JAZZ CAFE
6 Juegos de baquetas Promark Jazz Cafe. Baqueta de diametro 5A pero un poco más corta para situaciones delicadas. Bellota corn que produce un sonido oscuro en los platos. #yamaha #Sonor #Zildjian #Paiste #Premier #Meinl #percusión #crash #ride #pearl

Reina Roja / Red Queen (LA TRILOGÍA REINA ROJA)...
Nuevo

El profeta y la pandemia
Sin usar
DW DWSM2230 Pack Fieltros Protector y Palometa
DW DWSM2230 Pack Fieltros Protector y Palometa, Pack de protector, fieltro y palometa para soportes de plato. #Zildjian #Meinl #Paiste #Yamaha #Premier #Sonor #Mapex #Amedia #Percusión #Roland #Alexis #Pearl
Gretsch GTH-SL Soporte Tom
Soporte para tom Gretsch GTH-SL GR875010, con sistema de bola. Grosor del Rod en 'L' de 12,7mm Diámetro del tubo 25mm. #Zildjian #yamaha #Dw #Sonor #Premier
Soporte y banco para teclado
Se vende conjunto de soporte para teclado en forma de X y banco. - Soporte de teclado plegable. - Banco acolchado.
AKG C 1000 S Micrófonos
Se venden dos micrófonos AKG C 1000 S en sus estuches originales. Como se puede apreciar en las fotos, no ha salido nunca de casa y solo se ha utilizado para un home studio con muy pocas horas de uso. - Incluye dos micrófonos. - Cada micrófono viene en su maletín con espuma protectora. - Se incluyen accesorios y manuales. - Pinzas para soporte para micrófono. - Filtro antiviento. - Adaptador de rosca. #Zildjian #Meinl #Paiste #Yamaha #Premier #Sonor #Mapex #Amedia #Percusión #Roland #Alexis #Pearl #Shure #Makie
Teclado Korg TRITON Le 88
Teclado sintetizador Korg TRITON Le 88. - 88 teclas contrapesadas. - Pantalla LCD. - Conexiones MIDI IN/OUT. - Salidas de audio individuales y estéreo. - Entradas para pedal y switch. Nota: se prioriza entrega en mano debido a las dimensiones y peso. #piano, #yamaha, #teclado, #conservatorio, #clavinova, #casio
Petacas y receptores inalámbricos con estuche Thom
Petacas y receptores Akg más estuche Thonmann, ideal para transportar equipos. - Color negro. - Diseño robusto con perfiles de aluminio. - Asa integrada para facilitar el transporte.
Campos de fresas: No bailéis con la muerte
Libro de segunda mano un poco deteriorado por el filo y el lomo y escrito en boli solo la primera página pero el interior está en perfecto estado
Maribel y la extraña familia
Libro de segunda mano el cual se encuentra un poco deteriorado por el lomo y el filo de las páginas pero el interior está en perfecto estado.
Bajo Eléctrico MusicMan StingRay 4
Bajo eléctrico MusicMan StingRay 4 en acabado sunburst. - Cuerpo de madera con acabado degradado. - Pastilla humbucker negra. - Puente metálico cromado. - Tres potenciómetros plateados.
Bizcochos Irresistibles
Libro para hacer muchas variedades de bizcochos
Mi biblia
Se la regalaron a mi hijo por su comunión y tal como se la dieron la guardo en un cajón y nunca la uso, tiene una mancha en la parte de atrás de la pegatina que traía de venta por lo demás está como nuevo. está ilustrada con algunos dibujos es ideal.

Flauta dulce de madera color marrón
Flauta dulce de madera en tono marrón oscuro. Ideal para iniciarse en la música. - Diseño clásico con agujeros. - Acabado liso y elegante.
Caja de música Queen
Caja de música de madera con el logo de Queen. - Diseño grabado con el escudo de Queen. - Mecanismo musical visible.
Queen Sheer Heart Attack Vinilo LP
Disco de vinilo LP del álbum Sheer Heart Attack de Queen. - Portada icónica de la banda. - Edición en formato LP.

Queen Live Killers Disco Vinilo
Disco de vinilo del álbum Live Killers de Queen. - Portada icónica con la banda. - Sonido en vivo de alta calidad.
Queen - The Miracle Vinilo LP
Vinilo LP del álbum The Miracle de Queen. - Portada icónica con los rostros superpuestos. - Incluye el álbum completo.
Queen - A Kind of Magic Vinilo LP
Vinilo LP del álbum A Kind of Magic de Queen. La portada presenta un diseño artístico vibrante con los miembros de la banda. - Formato: Vinilo LP. - Artista: Queen. - Álbum: A Kind of Magic.
Queen The Vinyl Collection Nº 2
Disco de vinilo de la colección Queen The Vinyl Collection. - Edición número 2 de la colección. - Incluye el logo de Planeta DeAgostini.
Vinilo Queen
Disco de vinilo del grupo Queen. La portada muestra el logo de la banda en color rosa. - Formato LP.

Prepare Level 5 Student's Book with eBook (Camb...
está nuevo cualquier duda pregunten

Introducción y derechos de la persona vigesimonov
Muy nuevo
Lecciones de derecho penal parte general tomó I
Muy bien conservado
Los Foresteros Del Tiempo
lo recomiendo

Micrófono Karaoke Portátil WSTEX
Micrófono Karaoke WSTEX, ideal para principiantes. Es negro y tiene un diseño elegante. - Micrófono con altavoz incorporado. - Fácil de usar. - Diseño compacto y ligero.
Guitarra clásica - Instrumento musical
Guitarra clásica de color madera , en buen estado. - Cuerpo de madera. - Diapasón de madera oscura. - Clavijas en buen estado. - Acabado brillante. - Mide 97 de alto - Era para un regalo pero nunca lo llegué a dar esta sin utilizar .
Imágenes de los Nativos Americanos: Edward s. Curtis (Spanish Edition)
Impresionante libro construido con más de 300 fotografías tomadas por Edward Sheriff Curtis entre 1907 y 1930. Homenaje a la dignidad de los indios norteamericanos.
BUFFET SUCRE (MINI LIVRES DE CUISINE)
Pequeño libro de recetas de pastelería

Campos de fresas (Spanish Edition)
Libro, Campos de Fresa de Jordi Sierra
A orillas del mal (Paralelo Cero / Zero Parallel) (Spanish Edition)
Libro, A Orillas del mal de Francisco Díaz Valladares
Banco / sillín de batería Gibraltar
Banco de batería Gibraltar con asiento acolchado. - Asiento redondo y acolchado. - Base de trípode metálica. - Altura ajustable. Solo entrega en mano
Poptropica English Islands Level 3 Storycards
Story cards del libro Poptropica English Islands 3. Nuevo. Jamas usado. Con film protector colocado aun. De la editorial Pearson.
Poptropica English Islands Level 2 Storycards
Tarjetas de historia del libro Tropical Island. Poptropica English Islands 2 Story Cards. Completamente nuevo. Con el film protector colocado. Nunca se ha usado.
Complete Preliminary Teacher's Book with Downlo...
Libro Complete Preliminary Teacher’s book (second edition). Completamente nuevo, solo usado para comprobar tipos de ejercicios.
Psicología del desarrollo I (GRADO) (Spanish Ed...
Libro en buen estado, como se ve en las imágentes. Subrayado a lápiz.
Introducción al estudio de las diferencias indi...
Libro en buen estado, tal como se observa en las imágenes. Tiene los dos primeros temas subrayados como se ve, el resto sin subrayar.
Psicología del Lenguaje
Psicología del lenguaje, segunda edición. Libro en buen estado, subrayado a lápiz.
GUARDIANES DE LA NOCHE, 01 al 13
Colección 13 primeros libros de Guardianes de la Noche y Funko de regalo, de Makomo

Vinland Saga , envíos por parte del comprador
Español 1-28
Libro Goa Míriam Tirado sin estrenar
Libro Goa de Míriam Tirado, nuevo y sin estrenar. - Ilustraciones de Sheila de la Maza. - No m'ho puc creure!.
Colección VHS Félix Rodríguez de la Fuente
Colección completa de cintas VHS de Félix Rodríguez de la Fuente.
Colección VHS Jacques Cousteau
Colección de cintas VHS de El Mundo Desconocido de Jacques Cousteau. - Documentales sobre la vida marina y exploraciones. - Formato VHS. - Idioma español.
Clases y clases
Lectura obligatoria
libro de matemáticas 1 bachillerato
Se vende libro de matemáticas de ciencias, 1 bachillerato

Bajo
bajo car audio

Subwoofer JBL 1000W
Subwoofer JBL de 1000W en caja roja. Está en buenas condiciones. - Marca: JBL - Potencia: 1000W - Color de la caja: Rojo

Sony Xplod 1500W Bajo
Subwoofer Sony Xplod de 1500W en buen estado. Tiene algunos signos de uso, pero en general se encuentra en buenas condiciones. - Marca: Sony Xplod - Potencia: 1500W -
LEGO® Star Wars. El lado oscuro: (incluye una minifigura de un droide de combate)
Bonito libro de Star wars. No tengo la minifigura
Denon DJ Prime 2 Averiada
Controlador DJ Denon DJ Prime 2.
Controlador DJ Denon DJ Prime 2 (Avería)
Controlador DJ profesional Denon DJ Prime 2. Precio NO negociable. - Modelo: Prime 2 - Marca: Denon DJ - Tipo: Controlador DJ autónomo - Estado: Con avería, pantalla no enciende. Para cambiar pantalla o para piezas.

Póster Album Rvfv: "El Tiburón”
Póster del álbum El Tiburón de Rvfv. Incluye la portada y el listado de canciones. - Listado de 20 canciones. - Fecha de lanzamiento: 31/05/24. -Para mas información sobre tamaños y precios escribeme.

Póster Álbum JC Reyes Vivir Pa' Quedarse
Póster del álbum Vivir Pa' Quedarse de JC Reyes. - Incluye listado de canciones: 1. 2012 2. NO WAY 3. AVÍSAME 4. LOQUITA 5. RESTAS O SUMAS 6. SIEMPRE FIRME 7. MANO DE DIOS 8. ESCAPATE 9. YYY 10. TOY 11. MAKATUSSIN 12. YO Y TÚ 13. DA LA LUZ 14. DESDE 0 15. BARRIO FINO 16. PA LA CLÍNICA 17. FR33 BRO'S - Incluye código Spotify. - Fecha: 05/01/25.

Póster Clarent No Vuelve a Suceder
Póster del álbum No Vuelve a Suceder de Clarent. - Incluye la lista de canciones: 1. BIENVENIDA 2. BURROS 3. ESTA VIDA 4. BALLER FREESTYLE 5. OH MY 6. MALDAD 7. SCAT PACK 8. LOVE 9. OTRO MOMENTO 10. COMUNICADO - Incluye código Spotify. - Fecha: 08/01/26.

Póster Álbum Camin: "El Príncipe del Barrio”
Póster del álbum El Príncipe del Barrio de Camin. - Incluye listado de canciones. - Fecha de lanzamiento: 25/05/2023. - Para mas informacion sobre los precios y los tamaños escribeme.

Póster Álbum Bad Bunny: "Debi tirar mas fotos”
Póster del álbum "Debi tirar mas fotos” de Bad Bunny. - Incluye listado de canciones: NUEVAYOL, VOY A LLEVARTE PA PR, BAILE INOLVIDABLE, PERFUMITO NUEVO, WELTITA, VELDÁ, EL ClúB, KETU TECRÉ, BOKETE, KLOUFRENS, TURISTA, CAFÉ CON RON, PITORRO DE COCO, LO QUE LE PASÓ A HAWAII, EoO, DtMF, LA MUDANZA. - Fecha de lanzamiento: 05/01/25.
Póster personalizado de álbum musical
Crea tu propio póster de álbum musical con tu foto y detalles. - Espacio para foto del álbum. - Listado de canciones personalizable. - Campo para nombre del cantante. - Campo para nombre del álbum. - Espacio para fecha. - Incluye código QR de Spotify.
COLECCION DE "LOS FORASTEROS DEL TIEMPO”
6 libros de la coleccion "los forasteros del tiempo” de Roberto Santiago -Estan nuevos -Es una colección muy interesante hasta para los que no les gusta la lectura -Se pueden vender por separado
Mecano - Obras Completas (CD)
Completa discografía del grupo Mecano. SOLO ENVIO POR INPOST. - Incluye todos sus álbumes. - Formato CD.

Marina (Spanish Edition)
Ficción

Ángeles caídos
Policial

El pintor de Altamira
Libro

LA TENIENTE FARAH: El Jardín de las Mentiras
Novel policial

Tokio Blues (Norwegian Wood) (Spanish Edition)
Narrativa

Propios y extraños
Novela sobre la adopción de niños orientales
LIBRO DE ANIMALES
SE VENDEN DOS ENCICLOPEDIAS PARA LOS APASIONADOS DE LOS ANIMALES.
varios libros de primero
son varios libros de primero grado medio de farmacia. Todos los libros 100€ por separado pregunten precio.
Atlas Básico De Tecnología
Se trata de una colección de consulta y lectura muy bien conservada. Y muy ilustrada . Es fantástica. Sería colección completa por 25€ . Precio negociable.
EL MAXIMORTAL
¡Atención amantes del cómic de culto! 🚀 Pongo a la venta El Maximortal, la obra maestra de Rick Veitch (colaborador de Alan Moore en Swamp Thing). Una de las deconstrucciones más crudas, oscuras y brillantes del mito de Superman y de la propia industria del cómic. Detalles del ejemplar: • Edición: Norma Editorial, colección "El Día Después", número 10. • Autor: Rick Veitch. • Estado: Muy bueno. El lomo está entero y sin grietas de lectura, las páginas están bien conservadas y solo presenta el desgaste mínimo natural en las esquinas por el paso del tiempo. • Rareza: Actualmente es un tomo difícil de encontrar en librerías (descatalog
Pitt
Lote de Cómics PITT en muy buen estado.
Cuentos para niños de 5 años
Divertido y en perfecto estado.
El inversor inteligente: Un libro de asesoramie...
Buen Libro de Economía